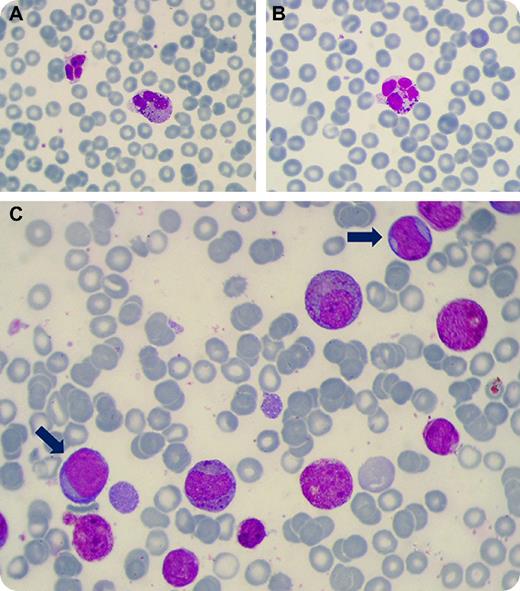
A 37-year-old man with no significant past family or personal medical history was admitted to the hospital for persistent eosinophilia detected during a routine check-up. He denied recent travel and was not a smoker, alcoholic, or drug addict. He did not have any history of allergic disease and was not exposed to any toxins or pesticides. Physical examination was normal. His complete blood examination revealed hemoglobin 122 g/dL, total leukocyte count 9 × 109/L with an absolute eosinophil count of 6 × 109/L; platelet count was 200 × 109/L. A peripheral blood film showed many morphologic abnormalities of eosinophils, including of size, granulation, and nuclear lobulation (panels A-B). Red blood cells and platelets were normal and there were no circulating blast cells. The bone marrow exhibited 45% to 55% eosinophilic hyperplasia and 30% of myeloid blast cells (panel C; blue arrows show blast cells). Abnormal eosinophils with dysplastic granules were present. / Molecular analysis on peripheral blood cells showed the rearrangement of FIP1L1-PDGFRA fusion gene. Other hematologic neoplasms or reactive eosinophilia were excluded. The patient was diagnosed with myeloproliferative neoplasm with eosinophilia and abnormalities of PDGFRA (according to the 2008 World Health Organization's Classification of Tumors of Hematopoietic and Lymphoid Tissues) with acute myeloid leukemia (AML). Most cases with rearranged PDGFRA have persistent chronic eosinophilia, but presentation as AML is uncommon. The patient responded to an earlier use of a tyrosine kinase inhibitor (Imatinib).

A 37-year-old man with no significant past family or personal medical history was admitted to the hospital for persistent eosinophilia detected during a routine check-up. He denied recent travel and was not a smoker, alcoholic, or drug addict. He did not have any history of allergic disease and was not exposed to any toxins or pesticides. Physical examination was normal. His complete blood examination revealed hemoglobin 122 g/dL, total leukocyte count 9 × 109/L with an absolute eosinophil count of 6 × 109/L; platelet count was 200 × 109/L. A peripheral blood film showed many morphologic abnormalities of eosinophils, including of size, granulation, and nuclear lobulation (panels A-B). Red blood cells and platelets were normal and there were no circulating blast cells. The bone marrow exhibited 45% to 55% eosinophilic hyperplasia and 30% of myeloid blast cells (panel C; blue arrows show blast cells). Abnormal eosinophils with dysplastic granules were present.
Molecular analysis on peripheral blood cells showed the rearrangement of FIP1L1-PDGFRA fusion gene. Other hematologic neoplasms or reactive eosinophilia were excluded. The patient was diagnosed with myeloproliferative neoplasm with eosinophilia and abnormalities of PDGFRA (according to the 2008 World Health Organization's Classification of Tumors of Hematopoietic and Lymphoid Tissues) with acute myeloid leukemia (AML). Most cases with rearranged PDGFRA have persistent chronic eosinophilia, but presentation as AML is uncommon. The patient responded to an earlier use of a tyrosine kinase inhibitor (Imatinib).
A 37-year-old man with no significant past family or personal medical history was admitted to the hospital for persistent eosinophilia detected during a routine check-up. He denied recent travel and was not a smoker, alcoholic, or drug addict. He did not have any history of allergic disease and was not exposed to any toxins or pesticides. Physical examination was normal. His complete blood examination revealed hemoglobin 122 g/dL, total leukocyte count 9 × 109/L with an absolute eosinophil count of 6 × 109/L; platelet count was 200 × 109/L. A peripheral blood film showed many morphologic abnormalities of eosinophils, including of size, granulation, and nuclear lobulation (panels A-B). Red blood cells and platelets were normal and there were no circulating blast cells. The bone marrow exhibited 45% to 55% eosinophilic hyperplasia and 30% of myeloid blast cells (panel C; blue arrows show blast cells). Abnormal eosinophils with dysplastic granules were present.
Molecular analysis on peripheral blood cells showed the rearrangement of FIP1L1-PDGFRA fusion gene. Other hematologic neoplasms or reactive eosinophilia were excluded. The patient was diagnosed with myeloproliferative neoplasm with eosinophilia and abnormalities of PDGFRA (according to the 2008 World Health Organization's Classification of Tumors of Hematopoietic and Lymphoid Tissues) with acute myeloid leukemia (AML). Most cases with rearranged PDGFRA have persistent chronic eosinophilia, but presentation as AML is uncommon. The patient responded to an earlier use of a tyrosine kinase inhibitor (Imatinib).
For additional images, visit the ASH IMAGE BANK, a reference and teaching tool that is continually updated with new atlas and case study images. For more information visit http://imagebank.hematology.org.
This feature is available to Subscribers Only
Sign In or Create an Account Close Modal